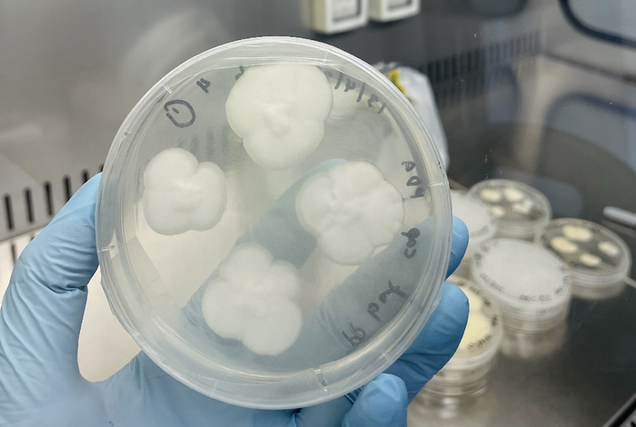

Discarded plastic is everywhere, mucking up natural and developed environments alike. Australian scientists say they’ve discovered two varieties of fungi that will eat away at the problem. In a study published this week, researchers from the University of Sydney report that fungi commonly found in dirt have broken…
Source: Gizmodo – Plastic-Devouring Fungi Boost Hope for Tackling Global Litter